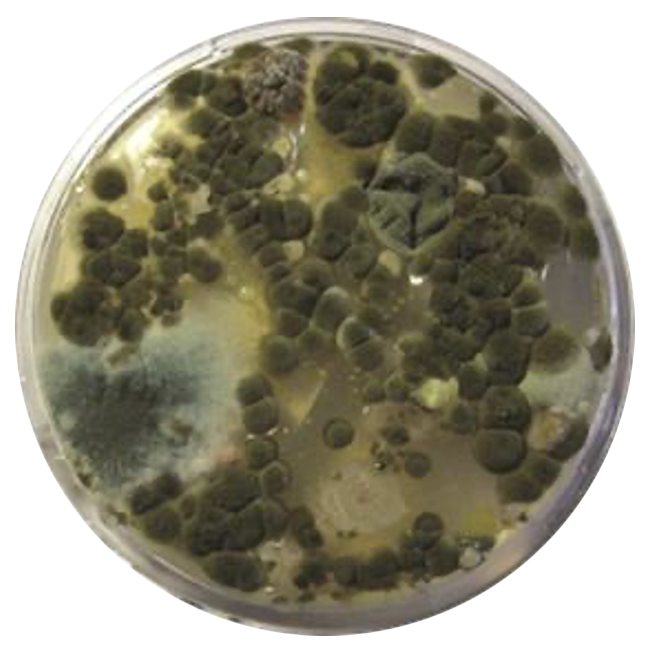

Répondez aux exigences du décret tertiaire
Depuis l’entrée en vigueur du décret tertiaire (issu de la loi ÉLAN), les propriétaires et gestionnaires de bâtiments tertiaires de plus de 1000 m² doivent réduire leur consommation d’énergie finale de 40 % d’ici 2030, 50 % d’ici 2040 et 60 % d’ici 2050.
Nos solutions UVC s’inscrivent pleinement dans cette démarche : elles apportent un gain énergétique mesurable et durable, particulièrement sur les centrales de traitement d’air (CTA), qui représentent souvent une part importante de la consommation des systèmes CVC.
Il a été démontré que l’intégration de la technologie UV-C dans les systèmes CVC permet de maintenir des serpentins plus propres, d’améliorer le flux d’air, l’efficacité des échanges thermiques et les performances globales du système. En réduisant l’accumulation microbienne et en améliorant l’efficacité opérationnelle, les systèmes UV-C peuvent générer des économies d’énergie de 10 à 35 %, tout en prolongeant la durée de vie des équipements et en réduisant les coûts de maintenance. (Source : Manuel ASHRAE)